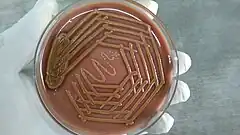
Description de cette image, également commentée ci-après

Sphingobacteriaceae
| Domaine | Bacteria |
|---|---|
| Embranchement | Bacteroidota |
| Classe | Sphingobacteriia |
| Ordre | Sphingobacteriales |
Famille
P. L. Steyn et al., 1998
La famille Sphingobacteriaceae fait partie de l'ordre des Sphingobacteriales du phylum Bacteroidota. Elle contient 14 genres de bactéries environnementales dont le genre type Sphingobacterium.
Description
La famille des Sphingobacteriaceae est décrite en 1998 par Steyn et placée en 2011 par Kämpfer dans l'ordre Sphingobacteriales[1],[2].
Taxonomie
Nomenclature
Le nom correct complet validé par l'ICSP (avec auteur) de ce taxon est Sphingobacteriaceae Steyn et al. 1998[3].
Étymologie
L'étymologie de la classe Sphingobacteriales est la suivante : N.L. neut. n. Sphingobacterium, genre type de l'ordre; L. fem. pl. n. suff. -aceae, suffixe définissant une famille; N.L. fem. pl. n. Sphingobacteriaceae, la famille de Sphingobacterium[4].
Liste des genres
Selon la LPSN (18 février 2023)[3], la famille Sphingobacteriaceae comprend 14 genres publiés de manière valide :
- Albibacterium García-López et al. 2020
- Anseongella Siddiqi et al. 2016
- Arcticibacter Prasad et al. 2013
- Daejeonella García-López et al. 2020
- Mucilaginibacter Pankratov et al. 2007
- Nubsella Asker et al. 2008
- Olivibacter Ntougias et al. 2007
- Parapedobacter Kim et al. 2007
- Pararcticibacter Cai et al. 2020
- Pedobacter Steyn et al. 1998
- Pelobium Xia et al. 2016
- Pseudopedobacter Cao et al. 2014
- Solitalea Weon et al. 2009
- Sphingobacterium (genre type) Yabuuchi et al. 1983
Genres non valides
Selon la LPSN (18 février 2023)[3], la famille Sphingobacteriaceae comprend le genre "Hevizibacter" qui est publié de manière non valide.
Genres synonymes
Le genre Pseudosphingobacterium placé dans cette famille est désormais un synonyme deu genre Olivibacter[4].
Références
- ↑ (en) P. Kämpfer, Bergey's Manual of Systematic Bacteriology, vol. 4, New York, Springer, (DOI 10.1007/978-0-387-68572-4), « Order I. Sphingobacteriales ord. nov. », p. 330
- ↑ Bergey's Manual of Systematic Bacteriology, 2nd ed., vol. 1 (The Archaea and the deeply branching and phototrophic Bacteria) (D.R. Boone and R.W. Castenholz, eds.), Springer-Verlag, New York (2001). pp. 465-466.
- 1 2 3 List of Prokaryotic names with Standing in Nomenclature (LPSN), consulté le 18 février 2023.
- 1 2 (en) « Family Sphingobacteriaceae », sur LPSN,
Liens externes
- Ressources relatives au vivant :
- (en) BioLib : Sphingobacteriaceae Steyn, Segers, Vancanneyt, Sandra, Kersters & Joubert, 1998 (consulté le )
- (en) Catalogue of Life : Sphingobacteriaceae Steyn et al., 1998 (consulté le )
- (fr + en) EOL : Sphingobacteriaceae (consulté le )
- (fr) INPN : Sphingobacteriaceae Steyn, Segers, Vancanneyt, Sandra, Kersters & Joubert, 1998 (TAXREF) (consulté le )
- (en) Taxonomicon : Sphingobacteriaceae Steyn et al. 1998 (consulté le )
- Portail de la microbiologie